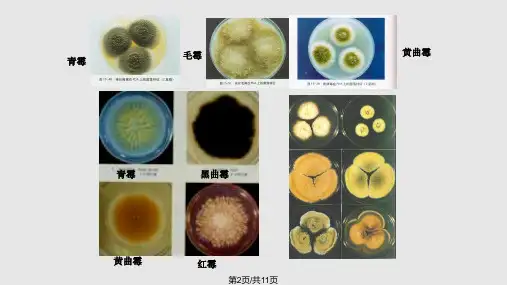

常见霉菌形态观察课件
- 格式:ppt
- 大小:1.78 MB
- 文档页数:163

实验五、霉菌的形态观察实验目的:1. 观察不同霉菌的形态特征,了解霉菌的分类及特点。
2. 掌握霉菌的常规培养方法,培养出真菌菌株。
实验材料:1. 感染性霉菌(如:麦角菌、白色念珠菌、鼠李糠霉等)。
2. 培养基(如:琼脂、马铃薯葡萄糖琼脂、配制糖酵母汤等)。
3. 恒温培养箱(28℃)。
4. 显微镜。
5. 盖玻片、载玻片、恒温水浴槽、升级滴管等。
实验步骤:1. 每个菌种需要分别制取接种物,用无菌棉签在菌落上插取的接种物涂于琼脂平板上。
2. 放到恒温箱中,在28℃的环境下孵育。
3. 观察培养基上菌落的生长形态、菌落颜色及其他特征,如球状、点状、菌丝状等。
4. 取一个干净的载玻片,使用无菌镊子将菌落切取一小块放置在载玻片上。
5. 在玻片上滴入少量的100%甘油,用盖玻片覆盖住,观察微镜下菌落的形态,如直链菌丝、弯曲链菌丝、无菌膜等。
6. 将制做好的预备液取出一滴,放置于玻片上,用显微镜观察。
液体涂片法需要先将菌落取出来悬浮在液体中,然后将悬浮液放在载玻片上。
在玻片上先滴上液体悬浮物,再盖上盖玻片,用显微镜观察。
7. 通过对霉菌形态学的观察,结合培养基上的生长情况,明确不同霉菌菌株的分类。
实验结果:霉菌是一类微生物,主要生长在植物、动物有机物上,具有不同的形态特征。
在实验中,我们通过对不同菌株的观察,发现它们各具特色,有些是球状的,有些是菌丝状的,有些则是点状的。
当我们加入甘油后,可以看到更加清晰细致的形态特征。
观察下来发现,同一种霉菌在不同的培养基上,生长形态也会有所不同。
因此人们通过对霉菌分子生物学、生理生化功能等方面的研究,初步对霉菌进行了分类,取得了一些重要的研究成果。
本实验主要通过观察不同菌株的形态特征,结合生长情况,对不同霉菌菌株进行了初步分类。
同时本实验也使我们更加了解了霉菌的基本特征,如生长环境,形态变化等,如今霉菌被广泛应用于很多领域的研究中,如食品工业、制药工业、生物技术等行业,为我们所知的现代科技发展带来更好的发展机遇。
